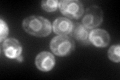
YGR260W

View description
High affinity nicotinic acid plasma membrane permease, responsible for uptake of low levels of nicotinic acid; expression of the gene increases in the absence of extracellular nicotinic acid or para-aminobenzoate (PABA)
Localization:
Intensity:
Fold change:
Significance:
-
C’ GFP library in SD
ER193.95 -
N' NOP1pr-GFP in SD

cell periphery,vacuole90.9742 -
N' TEF2pr-mCherry in SD

cell periphery,vacuole145.541 -
N' NATIVEpr-GFP in SD

vacuole30.6192 -
N' TEF2pr-VC and Cyto-VN in SD

punctate28.3498 -
C’ GFP library in SD+DTT

ER58.730.3Yes -
C’ GFP library in SD+H2O2

ER177.530.91No -
C’ GFP library in Starvation Media

ER25.270.13Yes -
C’ GFP library on the background of Pup2-DaMP

ER -
C’ GFP library on the background of CCT mutant

ER180.3820.930006No
